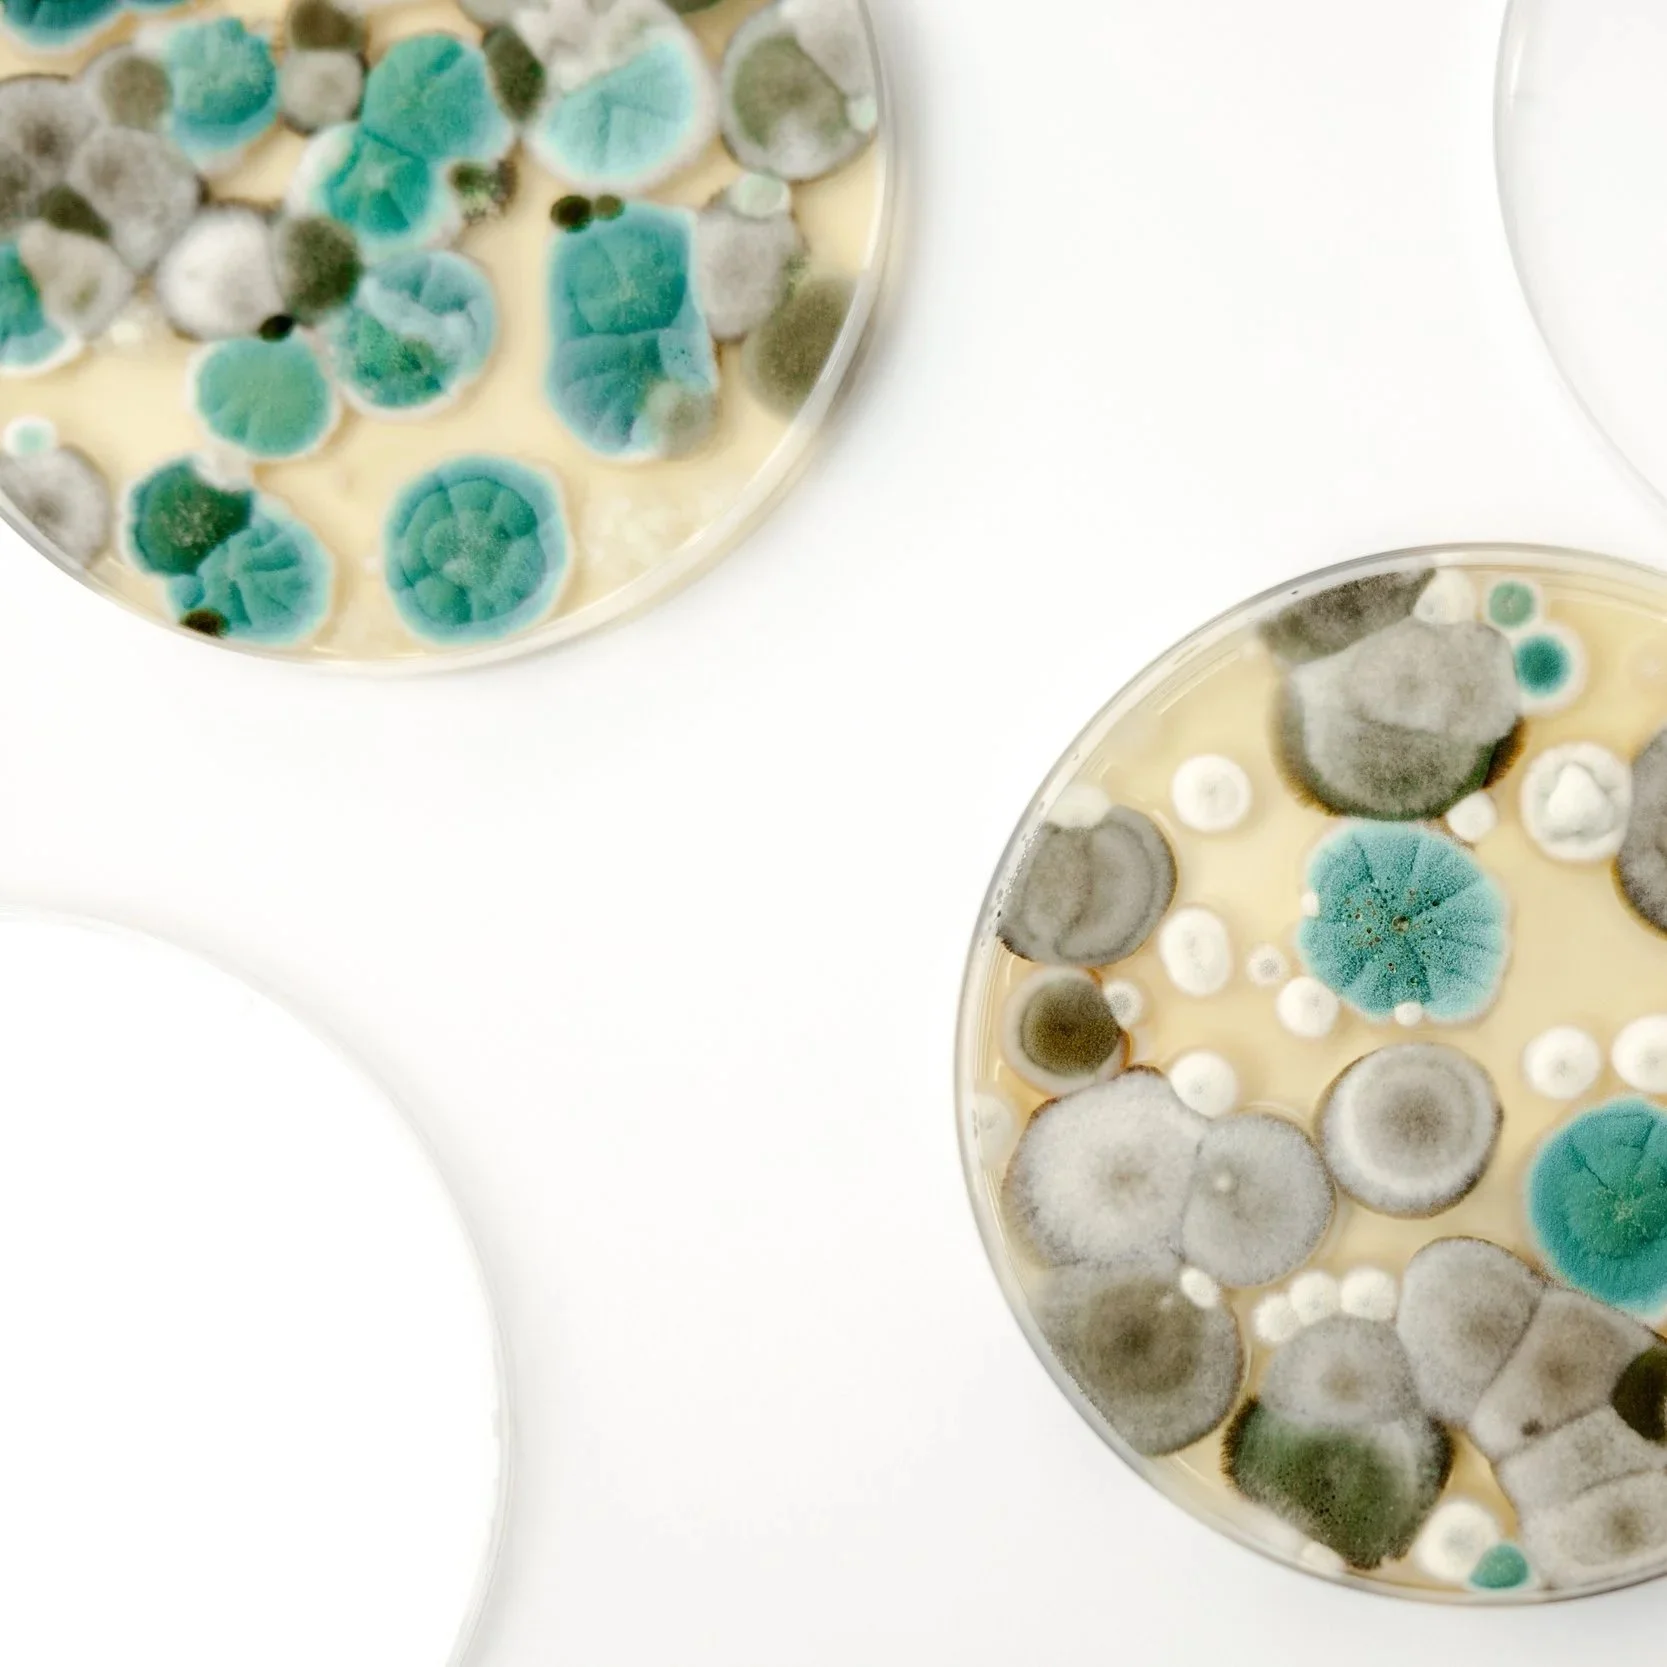

Pure Path Quality
Reaching
New Heights in
Quality & Compliance

Providing strategic leadership and technical expertise to help life sciences organizations achieve lasting success.

Explore What We Offer

Strategic quality leadership and technical expertise for biotech, pharmaceutical, and life sciences organizations.
Quality
&
Compliance
Strategy
Preparing for regulatory inspections, and harmonizing quality standards across global networks.
Sterility
Assurance
&
Microbiology

Developing and managing sterility assurance programs, contamination control strategies, and robust environmental and utility monitoring programs.
Laboratory
&
Facility
Startup
Leading QC laboratory design, method transfers, equipment qualification, and aseptic manufacturing start-up support.

Leadership
&
Team
Development
Offering interim or fractional QC/Microbiology leadership, and coaching to technical teams.

Operational
Excellence
Driving CAPA execution, continuous improvement initiatives, and data integrity compliance, ensuring processes meet business and regulatory goals.
With over three decades of experience in technical operations, QC leadership, and regulatory readiness, Carol helps organizations achieve compliance, operational efficiency, and sustainable quality culture.



Your Pure Path Guide
Carol Cheney is an accomplished quality and technical leader with over 30 years of experience in the biopharmaceutical industry, specializing in microbiology, quality control, sterility assurance, and regulatory compliance. She has led diverse teams in QC Microbiology, Sample Control, Virology, and Safety, overseeing laboratory design and qualification, environmental and utility monitoring programs, and method transfers. Her expertise spans the full product lifecycle, from start-up operations and technology transfer to regulatory inspections and global harmonization of control strategies. Known for her servant leadership approach, she fosters collaboration, develops high-performing teams, and drives continuous improvement to ensure operational excellence and regulatory readiness.
Throughout her career at leading organizations including Eli Lilly, Biogen, bluebird bio, Novo Nordisk, GlaxoSmithKline, Biolex Therapeutics, Eisai, and Nestlé USA, she has consistently delivered results by combining deep technical knowledge with strategic influence. She has successfully managed sterility assurance programs, implemented robust quality systems, led investigations and change controls, and represented sites in global governance forums and external audits. Carol’s ability to connect technical rigor with business priorities has enabled her to optimize processes, mitigate risks, and align multi-site operations to meet both corporate goals and regulatory expectations.
Education: Carol holds a Bachelor’s of Science degree with a focus on Microbiology from The Ohio State University and is an ASQ (American Society for Quality) Certified Quality Auditor.

Take the First Step…
Start your journey with Pure Path today.
Just submit this form, and we will be in touch shortly. Looking forward to hearing from you!